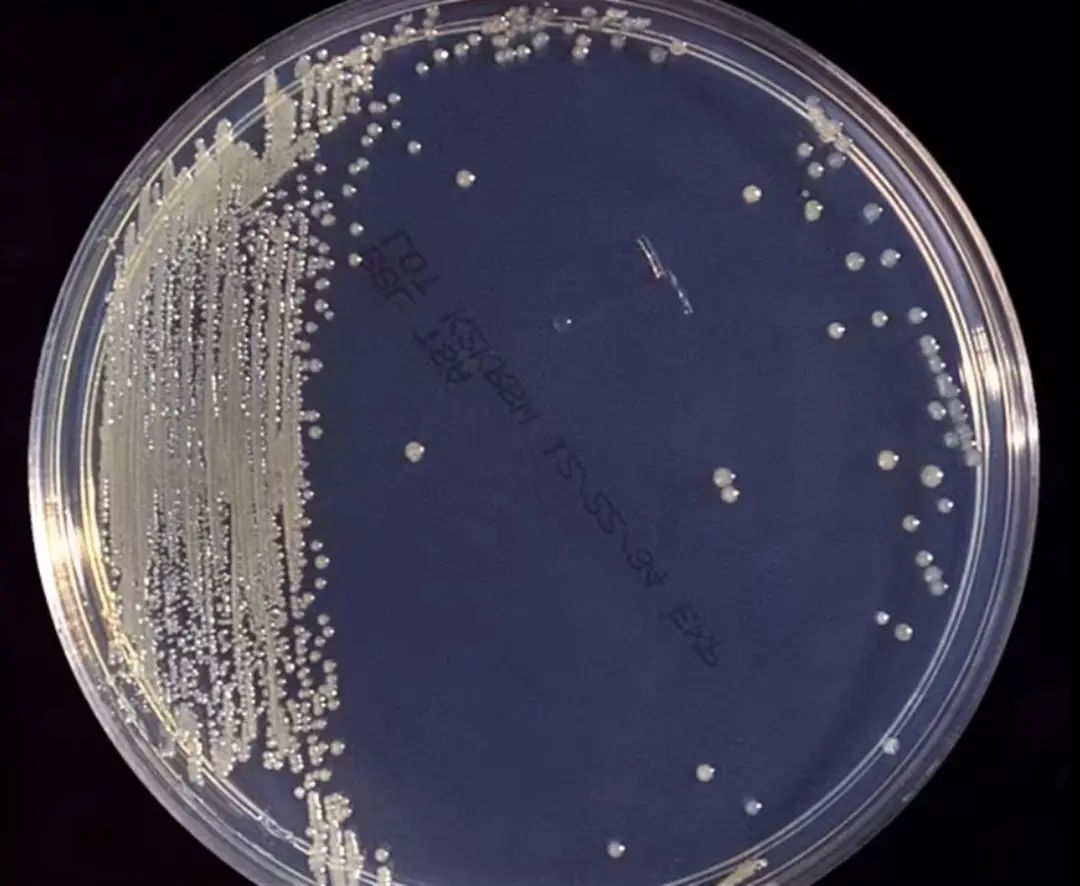

据《每日邮报》3月23日报道,美国食品和药物管理局(FDA)于当地时间3月22日晚发布了雅培奶粉致2名婴儿死亡案的调查结果:因雅培奶粉生产工厂有卫生安全问题,导致2名婴儿感染病菌死亡。

雅培工厂 图源:《每日邮报》
根据初步检查结果,这家工厂在生产和处理配方奶粉时工厂机器没有保持表面清洁。此外,检查人员还发现,在2019年秋季至今年2月之间,这家工厂曾8次检查出克罗诺杆菌。
克罗诺杆菌群 图源:《每日邮报》
2021年9月至2022年3月期间,在俄亥俄州食用雅培奶粉的孩子里,有5名婴儿住院和2名婴儿死亡。
根据FDA的说法,克罗诺杆菌感染的症状包括危及生命的感染,如败血症、脑膜炎、体温变化和肠道损伤。1 岁以下婴儿的首发症状通常是发烧,并伴有喂养不良、过度哭闹或精力不足,一些婴儿也可能会发作癫痫。
一对来自迈阿密父母表示,他们的孩子在喝了雅培奶粉后生病了,他们要求雅培负责。
最近的一位因食用雅培奶粉住院的婴儿是来自拉斯维加斯的两个月大的达维恩·琼斯,他于2月21日因身体出现严重脱水、皮疹和肠道问题住院。
达维恩的奶奶说:“我刚刚量了他的体温,都快40摄氏度了,整个人都红彤彤的。”
据悉,两个月以下的婴儿更容易出现更严重的并发症。
FDA随后可能会发布一份正式报告并对雅培进行警告。
雅培在一份声明中表示,公司“非常认真地对待此事,并与FDA密切合作,采取改进措施。”
据新华社2月21日报道,中国海关总署已发布公告,提醒消费者“暂不通过任何渠道购买”以及“立即暂停食用”美国雅培公司旗下相关婴幼儿产品。
据央视财经报道,今年2月,雅培全球官网主动召回三款婴儿配方奶粉,针对此事,雅培中国表示:此次主动召回的产品中,中国市场涉及婴儿营养补充剂喜康宝贝添,目前天猫、京东的雅培官方旗舰店已经下架这款商品。如消费者持有有效期为2022年4月1日起之后的喜康宝贝添产品,可拨打官方客服热线4008206111进行退货咨询。
原标题:《全球召回!知名品牌奶粉致2婴儿死亡,调查结果来了》
